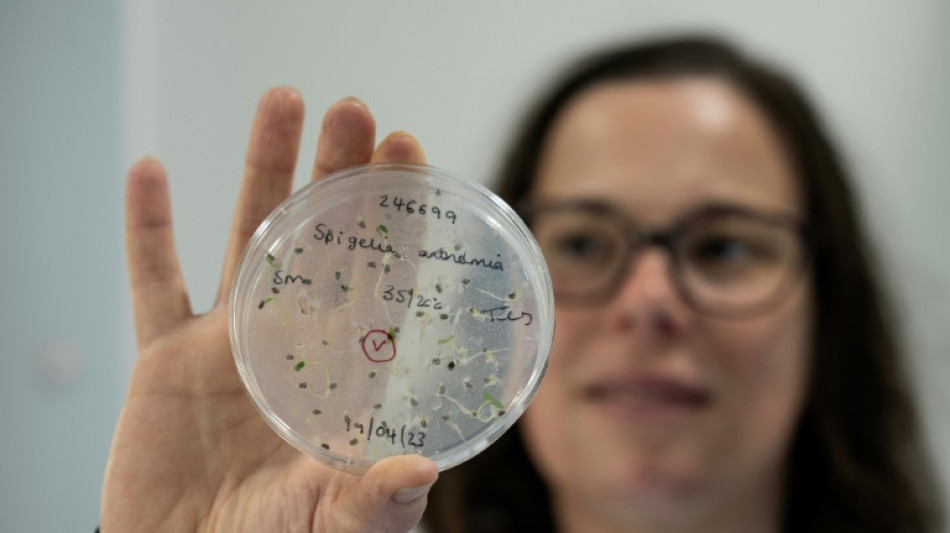
Inglaterra construye un arca de Noé subterránea con plantas de todo el mundo

Inglaterra construye un arca de Noé subterránea con plantas de todo el mundo
Las cámaras acorazadas están bajo tierra, en plena campiña inglesa, a una temperatura de 20º bajo cero. Pueden soportar inundaciones y bombardeos y guardan un tesoro formado por semillas de 40.000 plantas silvestres de todo el mundo, muchas de ellas en peligro de extinción.
El Banco de Semillas del Milenio (MSB, por sus siglas en inglés) lleva a cabo una carrera contrarreloj porque, según los científicos, dos de cada cinco especies vegetales del planeta corren el riesgo de desaparecer.
Este centro, situado al sur de Londres, es el mayor banco de semillas del mundo.
En opinión del biólogo David Attenborough, una figura de gran renombre en el Reino Unido, el MSB es "quizá la iniciativa de conservación más importante jamás realizada".
"El objetivo es conservar las especies silvestres mediante las semillas, para evitar que se extingan a largo plazo", explica John Dickie, responsable del proyecto.
Este investigador de 70 años está implicado en el MSB desde su creación a finales de los años 1990.
Se inauguró en 2000 para celebrar el milenio y se encuentra en Wakehurst, una sucursal de los jardines botánicos londinenses de Kew Gardens.
Aquí se almacenan unas 2.500 millones de semillas. Las hay de todas las formas, colores y tamaños. Pertenecen a 40.020 especies diferentes y proceden de 190 países. Representan casi el 20% de la flora mundial.
Se da prioridad a las plantas amenazadas, sobre todo por el cambio climático. Pero también a las plantas endémicas, que sólo pueden encontrarse en una zona geográfica específica.
Las plantas útiles para las comunidades desde el punto de vista médico o económico también tienen su lugar en Wakehurst.
"Las especies vegetales están amenazadas por varias razones (...), pero sobre todo por el cambio en el uso del suelo para la agricultura y, cada vez más, por el cambio climático", explica Dickie.
"Algunas plantas se adaptarán, otras no", pero "al menos estarán aquí, en lugar desaparecer del todo", agrega.
- Inundaciones, bombardeos, radiaciones -
Cada semana, en Wakehurst se reciben nuevas semillas y se inicia el proceso de salvarlas.
"Nuestra conservación de especies silvestres se basa en la tecnología ya utilizada para las especies cultivadas", explica Dickie. "No es complicado: se secan, se limpian y se congelan".
Una vez congeladas, las semillas pueden almacenarse durante décadas, probablemente siglos, asegura.
Su equipo trabaja a la vista del público en su laboratorio acristalado de Wakehurst. Hay unos 20 investigadores y algunos voluntarios.
Lucy Taylor trata semillas de albizia polyphylla, llegadas de Madagascar.
"Madagascar es un lugar muy interesante para los biólogos porque tiene una flora única, ya que la isla se separó de África. Además, hay mucha presión sobre el suelo" debido a la agricultura, explica.
Con paciencia, separa las semillas en mal estado del resto: "muchas están vacías o infestadas de insectos o enfermedades (...), pero nosotros queremos la mejor colección posible y no tenemos mucho espacio en nuestras cámaras".
Para detectar enfermedades, las semillas se someten a rayos X.
Cada una tiene su propia tarjeta de identidad, con su nombre, país de origen y fecha de llegada al MSB.
Se almacenan en frascos de cristal antes de ser congeladas en las cámaras subterráneas, construidas para resistir inundaciones, bombardeos y radiaciones.
La temperatura es de -20ºC. Los científicos entran en ellas vestidos como si trabajaran en una base polar.
La mayor colección de semillas corresponde a la familia de las orquídeas.
También hay plantas raras, como el nenúfar más pequeño del mundo o la deschampsia antarctica, conocida igualmente como hierba capilar antártica, una de las dos plantas con flor autóctonas del polo sur.
La MSB, que recibe financiación pública y donaciones, colabora con 90 países.
Algunos, como Indonesia, se niegan a compartir sus semillas con esta institución, pero las conservan en su territorio.
Otras, sin embargo, parecen fuera de su alcance: uno de los pocos pesares de Dickie es no tener intercambios con Irán.
D.Chapman--MC-UK




